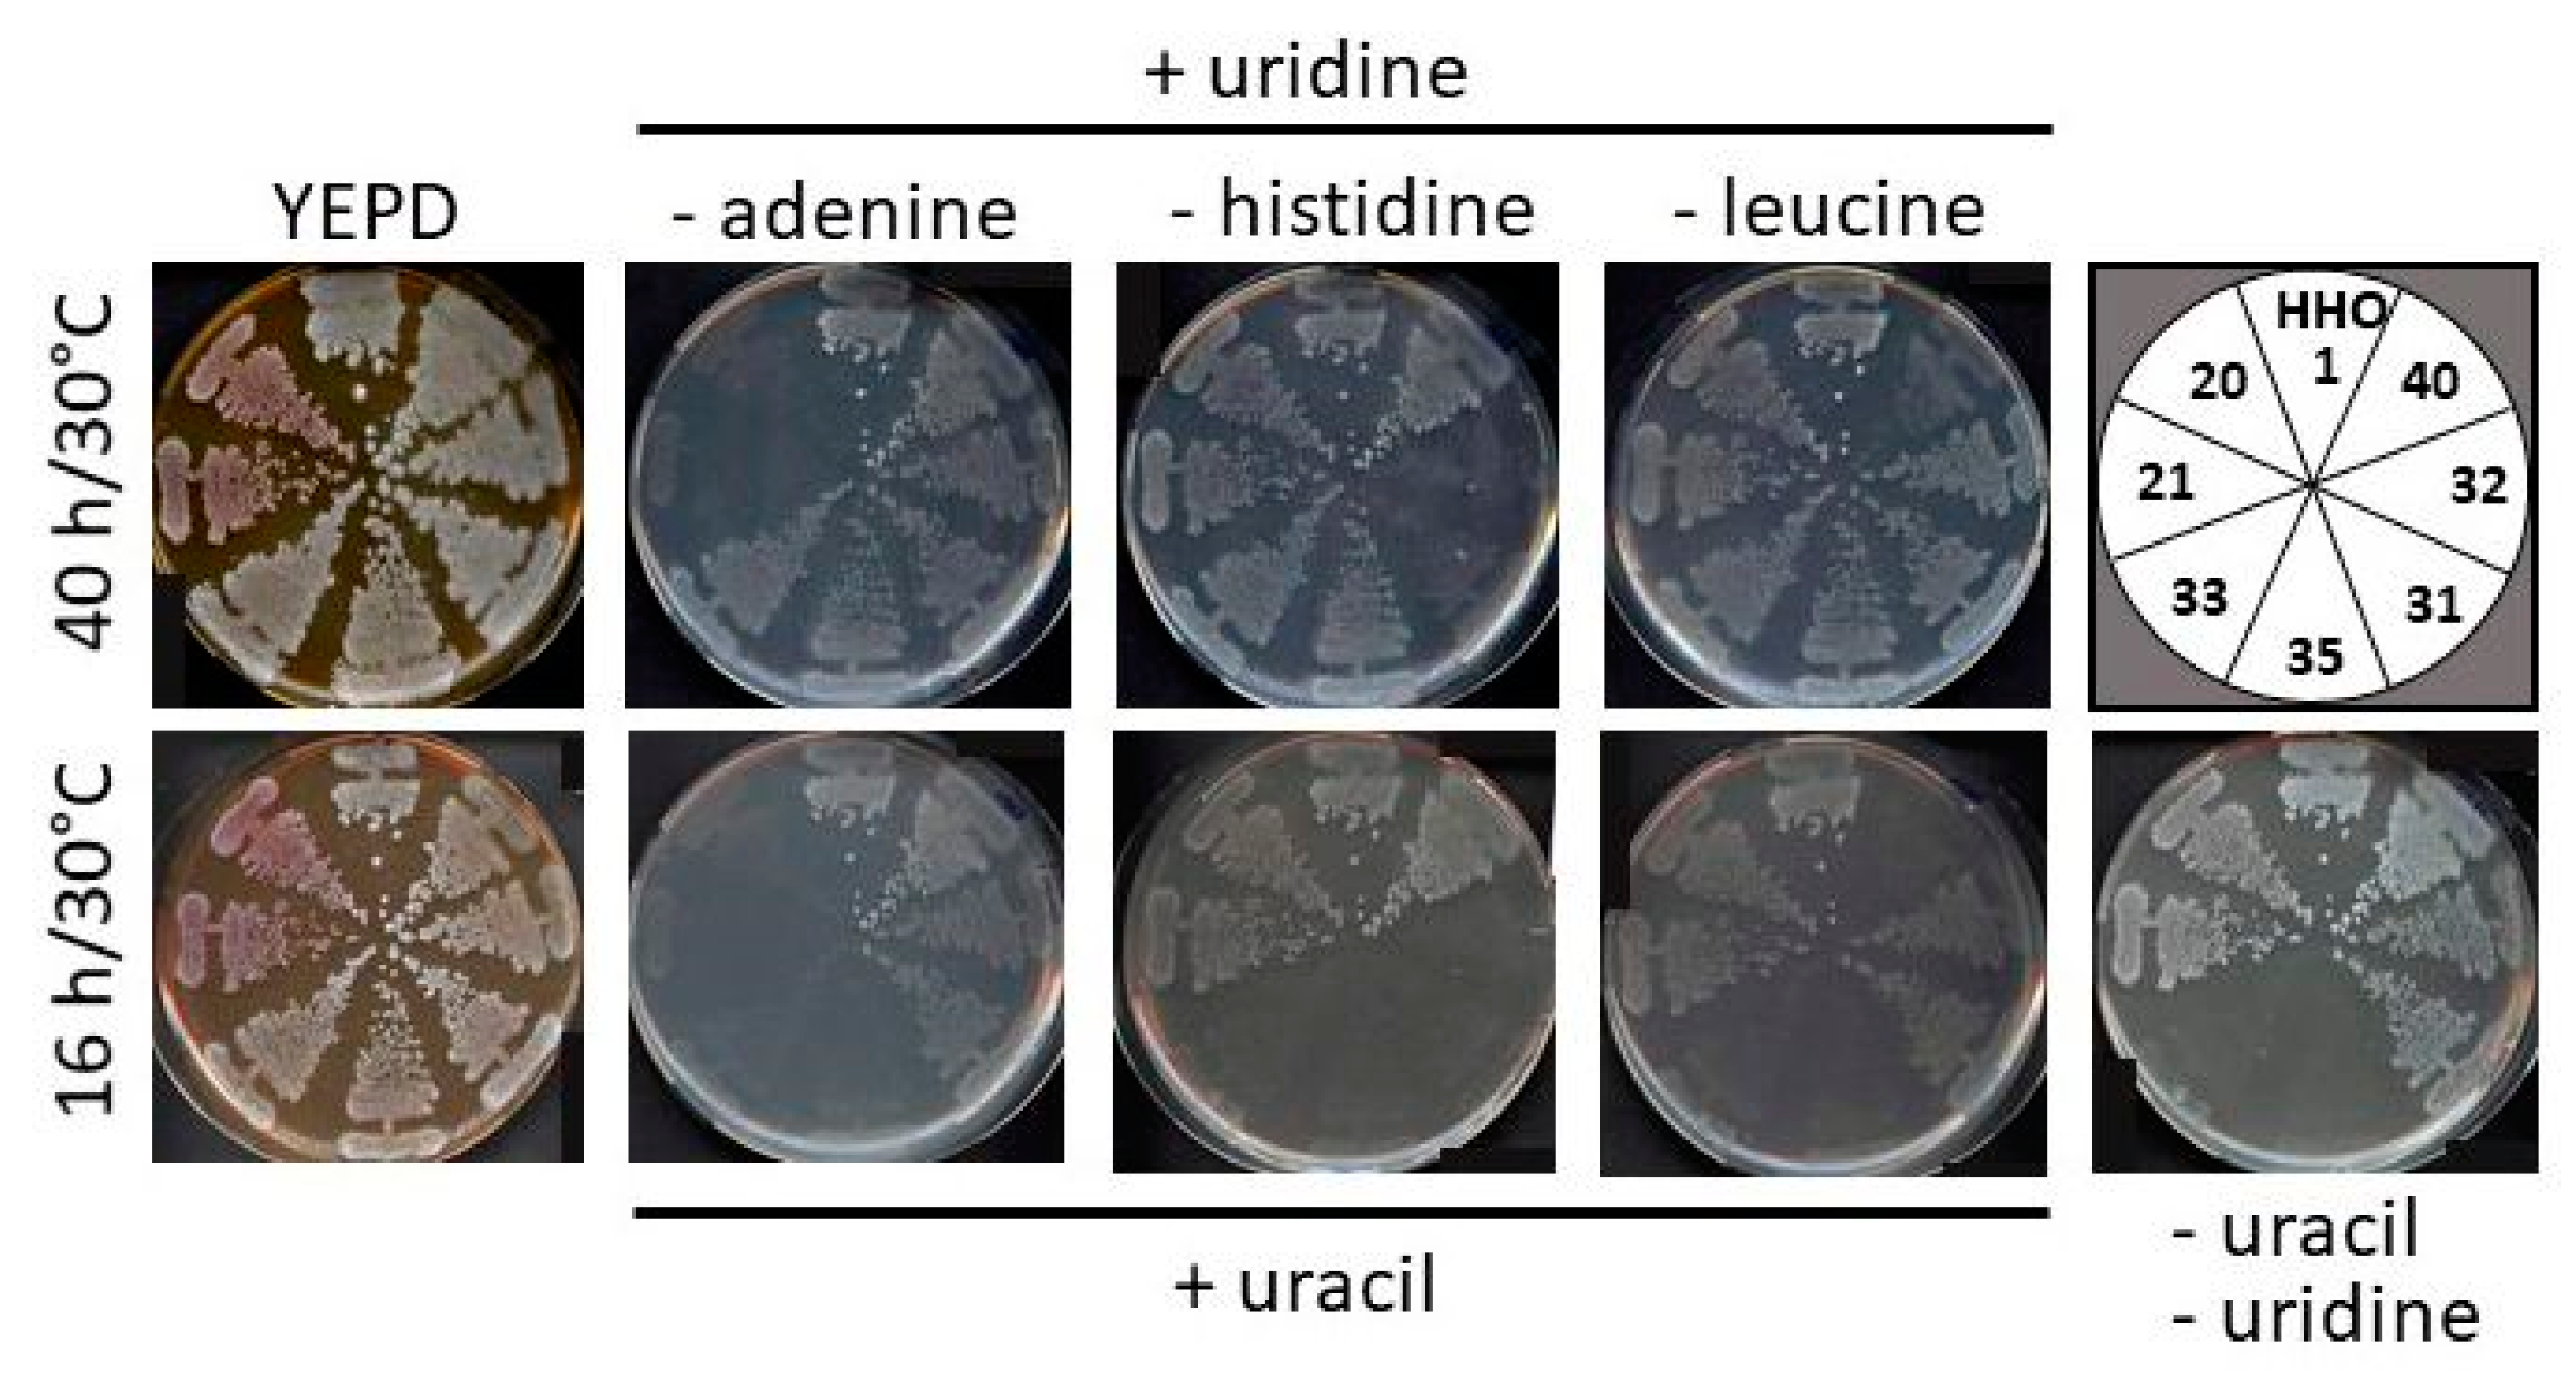

A Versatile Toolset for Genetic Manipulation of the Wine Yeast Hanseniaspora uvarum
Abstract
1. Introduction
2. Results
2.1. Characterization of the HHO1 Recipient Strain
2.2. Cloning and Characterization of Chromosomal Replication Origins
2.3. Construction of Recyclable Deletion Cassettes and Cloning Vectors
2.4. Construction of Strains with Auxotrophic Selection Markers and Determination of Transformation Efficiencies
2.5. Establishment of a Chemical Transformation Procedure
3. Discussion
4. Materials and Methods
4.1. Strains, Media, and Growth Conditions
4.2. Transformation Procedures
4.3. Construction of Plasmids and Deletion Mutants
4.4. DNA Preparations and PCR
4.5. Imaging
Supplementary Materials
Author Contributions
Funding
Institutional Review Board Statement
Informed Consent Statement
Data Availability Statement
Acknowledgments
Conflicts of Interest
Abbreviations
References
- Chambers, P.J.; Pretorius, I.S. Fermenting knowledge: The history of winemaking, science and yeast research. EMBO Rep. 2010, 11, 914–920. [Google Scholar] [CrossRef]
- Drumonde-Neves, J.; Franco-Duarte, R.; Lima, T.; Schuller, D.; Pais, C. Yeast biodiversity in vineyard environments is increased by human intervention. PLoS ONE 2016, 11, e0160579. [Google Scholar] [CrossRef] [PubMed]
- Fleet, G.H. Yeast interactions and wine flavour. Int. J. Food Microbiol. 2003, 86, 11–22. [Google Scholar] [CrossRef]
- Tufariello, M.; Fragasso, M.; Pico, J.; Panighel, A.; Castellarin, S.D.; Flamini, R.; Grieco, F. Influence of non-Saccharomyces on wine chemistry: A focus on aroma-related compounds. Molecules 2021, 26, 644. [Google Scholar] [CrossRef] [PubMed]
- Kachalkin, A.; Glushakova, A.; Streletskii, R. Diversity of endophytic yeasts from agricultural fruits positive for phytohormone IAA production. BioTech 2022, 11, 38. [Google Scholar] [CrossRef] [PubMed]
- Liu, Z.; Tian, J.; Yan, H.; Li, D.; Wang, X.; Liang, W.; Wang, G. Ethyl acetate produced by Hanseniaspora uvarum is a potential biocontrol agent against tomato fruit rot caused by Phytophthora nicotianae. Front. Microbiol. 2022, 13, 978920. [Google Scholar] [CrossRef]
- Skotniczny, M.; Satora, P.; Panczyszyn, K.; Cioch-Skoneczny, M. Growth dynamics and diversity of yeasts during spontaneous plum mash fermentation of different varieties. Foods 2020, 9, 1054. [Google Scholar] [CrossRef]
- Wang, L.; Dou, G.; Guo, H.; Zhang, Q.; Qin, X.; Yu, W.; Jiang, C.; Xiao, H. Volatile organic compounds of Hanseniaspora uvarum increase strawberry fruit flavor and defense during cold storage. Food Sci. Nutr. 2019, 7, 2625–2635. [Google Scholar] [CrossRef]
- Batista, N.N.; Ramos, C.L.; Dias, D.R.; Pinheiro, A.C.; Schwan, R.F. The impact of yeast starter cultures on the microbial communities and volatile compounds in cocoa fermentation and the resulting sensory attributes of chocolate. J. Food Sci. Technol. 2016, 53, 1101–1110. [Google Scholar] [CrossRef]
- Masoud, W.; Cesar, L.B.; Jespersen, L.; Jakobsen, M. Yeast involved in fermentation of Coffea arabica in East Africa determined by genotyping and by direct denaturating gradient gel electrophoresis. Yeast 2004, 21, 549–556. [Google Scholar] [CrossRef]
- Gomez-Albarran, C.; Melguizo, C.; Patino, B.; Vazquez, C.; Gil-Serna, J. Diversity of mycobiota in Spanish grape berries and selection of Hanseniaspora uvarum U1 to prevent mycotoxin contamination. Toxins 2021, 13, 649. [Google Scholar] [CrossRef] [PubMed]
- Liu, H.M.; Guo, J.H.; Cheng, Y.J.; Liu, P.; Long, C.A.; Deng, B.X. Inhibitory activity of tea polyphenol and Hanseniaspora uvarum against Botrytis cinerea infections. Lett. Appl. Microbiol. 2010, 51, 258–263. [Google Scholar] [CrossRef]
- Tejero, P.; Martin, A.; Rodriguez, A.; Galvan, A.I.; Ruiz-Moyano, S.; Hernandez, A. In vitro biological control of Aspergillus flavus by Hanseniaspora opuntiae L479 and Hanseniaspora uvarum L793, producers of antifungal volatile organic compounds. Toxins 2021, 13, 663. [Google Scholar] [CrossRef] [PubMed]
- Zhang, Q.Q.; Shi, J.; Shen, P.Y.; Xi, F.; Qian, C.Y.; Zhang, G.H.; Zhu, H.J.; Xiao, H.M. Exploring the efficacy of biocontrol microbes against the fungal pathogen Botryosphaeria dothidea JNHT01 isolated from fresh walnut fruit. Foods 2022, 11, 3651. [Google Scholar] [CrossRef] [PubMed]
- Little, C.M.; Chapman, T.W.; Hillier, N.K. Plasticity is key to success of Drosophila suzukii (Diptera: Drosophilidae) invasion. J. Insect Sci. 2020, 20, 1–8. [Google Scholar] [CrossRef]
- Jones, R.; Fountain, M.T.; Andreani, N.A.; Gunther, C.S.; Goddard, M.R. The relative abundances of yeasts attractive to Drosophila suzukii differ between fruit types and are greatest on raspberries. Sci. Rep. 2022, 12, 10382. [Google Scholar] [CrossRef]
- Kleman, I.; Rehermann, G.; Kwadha, C.A.; Witzgall, P.; Becher, P.G. Hanseniaspora uvarum attracts Drosophila suzukii (Diptera: Drosophilidae) with high specificity. J. Econ. Entomol. 2022, 115, 999–1007. [Google Scholar] [CrossRef]
- Schmitt, M.J.; Poravou, O.; Trenz, K.; Rehfeldt, K. Unique double-stranded RNAs responsible for the anti-Candida activity of the yeast Hanseniaspora uvarum. J. Virol. 1997, 71, 8852–8855. [Google Scholar] [CrossRef]
- Jolly, N.P.; Varela, C.; Pretorius, I.S. Not your ordinary yeast: Non-Saccharomyces yeasts in wine production uncovered. FEMS Yeast Res. 2014, 14, 215–237. [Google Scholar] [CrossRef]
- Zott, K.; Miot-Sertier, C.; Claisse, O.; Lonvaud-Funel, A.; Masneuf-Pomarede, I. Dynamics and diversity of non-Saccharomyces yeasts during the early stages in winemaking. Int. J. Food Microbiol. 2008, 125, 197–203. [Google Scholar] [CrossRef] [PubMed]
- Borren, E.; Tian, B. The important contribution of non-Saccharomyces yeasts to the aroma complexity of wine: A review. Foods 2020, 10, 13. [Google Scholar] [CrossRef] [PubMed]
- Ciani, M.; Beco, L.; Comitini, F. Fermentation behaviour and metabolic interactions of multistarter wine yeast fermentations. Int. J. Food Microbiol. 2006, 108, 239–245. [Google Scholar] [CrossRef] [PubMed]
- Huang, M.; Liu, X.; Li, X.; Sheng, X.; Li, T.; Tang, W.; Yu, Z.; Wang, Y. Effect of Hanseniaspora uvarum-Saccharomyces cerevisiae mixed fermentation on aroma characteristics of Rosa roxburghii Tratt, blueberry, and plum wines. Molecules 2022, 27, 8097. [Google Scholar] [CrossRef]
- Martin, V.; Valera, M.J.; Medina, K.; Boido, E.; Carrau, F. Oenological impact of the Hanseniaspora/Kloeckera yeast genus on wines—A review. Fermentation 2018, 4, 76. [Google Scholar] [CrossRef]
- Pietrafesa, A.; Capece, A.; Pietrafesa, R.; Bely, M.; Romano, P. Saccharomyces cerevisiae and Hanseniaspora uvarum mixed starter cultures: Influence of microbial/physical interactions on wine characteristics. Yeast 2020, 37, 609–621. [Google Scholar] [CrossRef] [PubMed]
- Nisiotou, A.; Mallouchos, A.; Tassou, C.; Banilas, G. Indigenous yeast interactions in dual-starter fermentations may improve the varietal expression of Moschofilero wine. Front. Microbiol. 2019, 10, 1712. [Google Scholar] [CrossRef] [PubMed]
- Canonico, L.; Comitini, F.; Oro, L.; Ciani, M. Sequential fermentation with selected immobilized non-Saccharomyces yeast for reduction of ethanol content in wine. Front. Microbiol. 2016, 7, 278. [Google Scholar] [CrossRef]
- Zhu, X.; Navarro, Y.; Mas, A.; Torija, M.J.; Beltran, G. A rapid method for selecting non-Saccharomyces strains with a low ethanol yield. Microorganisms 2020, 8, 658. [Google Scholar] [CrossRef]
- Bezerra-Bussoli, C.; Baffi, M.A.; Gomes, E.; Da-Silva, R. Yeast diversity isolated from grape musts during spontaneous fermentation from a Brazilian winery. Curr. Microbiol. 2013, 67, 356–361. [Google Scholar] [CrossRef]
- Venturin, C.; Boze, H.; Moulin, G.; Galzy, P. Glucose metabolism, enzymic analysis and product formation in chemostat culture of Hanseniaspora uvarum. Yeast 1995, 11, 327–336. [Google Scholar] [CrossRef]
- Langenberg, A.K.; Bink, F.J.; Wolff, L.; Walter, S.; von Wallbrunn, C.; Grossmann, M.; Heinisch, J.J.; Schmitz, H.P. Glycolytic functions are conserved in the genome of the wine yeast Hanseniaspora uvarum, and pyruvate kinase limits its capacity for alcoholic fermentation. Appl. Environ. Microbiol. 2017, 83, e01580-17. [Google Scholar] [CrossRef] [PubMed]
- Mencher, A.; Morales, P.; Valero, E.; Tronchoni, J.; Patil, K.R.; Gonzalez, R. Proteomic characterization of extracellular vesicles produced by several wine yeast species. Microb. Biotechnol. 2020, 13, 1581–1596. [Google Scholar] [CrossRef] [PubMed]
- Masneuf-Pomarede, I.; Bely, M.; Marullo, P.; Albertin, W. The genetics of non-conventional wine yeasts: Current knowledge and future challenges. Front. Microbiol. 2015, 6, 1563. [Google Scholar] [CrossRef] [PubMed]
- Guaragnella, N.; Chiara, M.; Capece, A.; Romano, P.; Pietrafesa, R.; Siesto, G.; Manzari, C.; Pesole, G. Genome sequencing and comparative analysis of three Hanseniaspora uvarum indigenous wine strains reveal remarkable biotechnological potential. Front. Microbiol. 2019, 10, 3133. [Google Scholar] [CrossRef] [PubMed]
- Sternes, P.R.; Lee, D.; Kutyna, D.R.; Borneman, A.R. Genome sequences of three species of Hanseniaspora isolated from spontaneous wine fermentations. Genome Announc. 2016, 4, e01287-16. [Google Scholar] [CrossRef]
- Saubin, M.; Devillers, H.; Proust, L.; Brier, C.; Grondin, C.; Pradal, M.; Legras, J.L.; Neuveglise, C. Investigation of genetic relationships between Hanseniaspora species found in grape musts revealed interspecific hybrids with dynamic genome structures. Front. Microbiol. 2019, 10, 2960. [Google Scholar] [CrossRef]
- Badura, J.; van Wyk, N.; Brezina, S.; Pretorius, I.S.; Rauhut, D.; Wendland, J.; von Wallbrunn, C. Development of genetic modification tools for Hanseniaspora uvarum. Int. J. Mol. Sci. 2021, 22, 1943. [Google Scholar] [CrossRef]
- Bink, F.J. Molekulargenetische und physiologische Untersuchungen an der Weinhefe Kloeckera apiculata (Hanseniaspora uvarum). Ph.D. Thesis, Department of Biology and Chemistry, University of Osnabrück, Osnabrück, Germany, 2010. [Google Scholar]
- Wang, D.; Lai, F.L.; Gao, F. Ori-Finder 3: A web server for genome-wide prediction of replication origins in Saccharomyces cerevisiae. Brief Bioinform. 2021, 22, bbaa182. [Google Scholar] [CrossRef]
- Bailey, T.L.; Johnson, J.; Grant, C.E.; Noble, W.S. The MEME Suite. Nucleic Acids Res. 2015, 43, W39–W49. [Google Scholar] [CrossRef]
- Gueldener, U.; Heinisch, J.; Koehler, G.J.; Voss, D.; Hegemann, J.H. A second set of loxP marker cassettes for Cre-mediated multiple gene knockouts in budding yeast. Nucleic Acids Res. 2002, 30, e23. [Google Scholar] [CrossRef]
- Hegemann, J.H.; Heick, S.B. Delete and repeat: A comprehensive toolkit for sequential gene knockout in the budding yeast Saccharomyces cerevisiae. Methods Mol. Biol. 2011, 765, 189–206. [Google Scholar]
- Hill, J.E.; Myers, A.M.; Koerner, T.J.; Tzagoloff, A. Yeast/E. coli shuttle vectors with multiple unique restriction sites. Yeast 1986, 2, 163–167. [Google Scholar] [CrossRef] [PubMed]
- Klebe, R.J.; Harriss, J.V.; Sharp, Z.D.; Douglas, M.G. A general method for polyethylene-glycol-induced genetic transformation of bacteria and yeast. Gene 1983, 25, 333–341. [Google Scholar] [CrossRef] [PubMed]
- Gietz, R.D.; Schiestl, R.H.; Willems, A.R.; Woods, R.A. Studies on the transformation of intact yeast cells by the LiAc/SS-DNA/PEG procedure. Yeast 1995, 11, 355–360. [Google Scholar] [CrossRef] [PubMed]
- Liachko, I.; Youngblood, R.A.; Keich, U.; Dunham, M.J. High-resolution mapping, characterization, and optimization of autonomously replicating sequences in yeast. Genome Res. 2013, 23, 698–704. [Google Scholar] [CrossRef]
- Rodicio, R.; Heinisch, J.J. Yeast on the milky way: Genetics, physiology and biotechnology of Kluyveromyces lactis. Yeast 2013, 30, 165–177. [Google Scholar] [CrossRef]
- Murray, A.W.; Szostak, J.W. Pedigree analysis of plasmid segregation in yeast. Cell 1983, 34, 961–970. [Google Scholar] [CrossRef]
- Sinclair, D.A.; Guarente, L. Extrachromosomal rDNA circles--a cause of aging in yeast. Cell 1997, 91, 1033–1042. [Google Scholar] [CrossRef]
- Wach, A.; Brachat, A.; Pohlmann, R.; Philippsen, P. New heterologous modules for classical or PCR-based gene disruptions in Saccharomyces cerevisiae. Yeast 1994, 10, 1793–1808. [Google Scholar] [CrossRef]
- Hieter, P.; Mann, C.; Snyder, M.; Davis, R.W. Mitotic stability of yeast chromosomes: A colony color assay that measures nondisjunction and chromosome loss. Cell 1985, 40, 381–392. [Google Scholar] [CrossRef]
- Haase, M.A.B.; Truong, D.M.; Boeke, J.D. Superloser: A plasmid shuffling vector for Saccharomyces cerevisiae with exceedingly low background. G3 2019, 9, 2699–2707. [Google Scholar] [CrossRef] [PubMed]
- Silva, R.; Aguiar, T.Q.; Oliveira, C.; Domingues, L. Physiological characterization of a pyrimidine auxotroph exposes link between uracil phosphoribosyltransferase regulation and riboflavin production in Ashbya gossypii. Nat. Biotechnol. 2019, 50, 1–8. [Google Scholar] [CrossRef] [PubMed]
- Heinisch, J.J.; Buchwald, U.; Gottschlich, A.; Heppeler, N.; Rodicio, R. A tool kit for molecular genetics of Kluyveromyces lactis comprising a congenic strain series and a set of versatile vectors. FEMS Yeast Res. 2010, 10, 333–342. [Google Scholar] [CrossRef] [PubMed]
- Bernardi, B.; Kayacan, Y.; Akan, M.; Wendland, J. Overexpression of RAD51 enables PCR-based gene targeting in lager yeast. Microorganisms 2019, 7, 192. [Google Scholar] [CrossRef] [PubMed]
- Arvanitidis, A.; Heinisch, J.J. Studies on the function of yeast phosphofructokinase subunits by in vitro mutagenesis. J. Biol. Chem. 1994, 269, 8911–8918. [Google Scholar] [CrossRef] [PubMed]
- Kirchrath, L.; Lorberg, A.; Schmitz, H.P.; Gengenbacher, U.; Heinisch, J.J. Comparative genetic and physiological studies of the MAP kinase Mpk1p from Kluyveromyces lactis and Saccharomyces cerevisiae. J. Mol. Biol. 2000, 300, 743–758. [Google Scholar] [CrossRef] [PubMed]
- Rose, M.D.; Winston, F.; Hieter, P. (Eds.) Methods in Yeast Genetics—A Laboratory Course Manual; Cold Spring Harbor Laboratory Press: New York, NY, USA, 1990. [Google Scholar]
- Straede, A.; Heinisch, J.J. Functional analyses of the extra- and intracellular domains of the yeast cell wall integrity sensors Mid2 and Wsc. FEBS Lett. 2007, 581, 4495–4500. [Google Scholar] [CrossRef]
- Heinisch, J.J. PFK2, ISP42, ERG2 and RAD14 are located on the right arm of chromosome XIII. Yeast 1993, 9, 1103–1105. [Google Scholar] [CrossRef]
- Rothstein, R. Targeting, disruption, replacement, and allele rescue: Integrative DNA transformation in yeast. Methods Enzymol. 1991, 194, 281–301. [Google Scholar]
- Gietz, R.D.; Sugino, A. New yeast-Escherichia coli shuttle vectors constructed with in vitro mutagenized yeast genes lacking six-base pair restriction sites. Gene 1988, 74, 527–534. [Google Scholar] [CrossRef]
- Rodicio, R.; Koch, S.; Schmitz, H.P.; Heinisch, J.J. KlRHO1 and KlPKC1 are essential for cell integrity signalling in Kluyveromyces lactis. Microbiology 2006, 152, 2635–2649. [Google Scholar] [CrossRef] [PubMed]
- Schmitz, H.P.; Jendretzki, A.; Wittland, J.; Wiechert, J.; Heinisch, J.J. Identification of Dck1 and Lmo1 as upstream regulators of the small GTPase Rho5 in Saccharomyces cerevisiae. Mol. Microbiol. 2015, 96, 306–324. [Google Scholar] [CrossRef] [PubMed]
- Rippert, D.; Heppeler, N.; Albermann, S.; Schmitz, H.P.; Heinisch, J.J. Regulation of cytokinesis in the milk yeast Kluyveromyces lactis. Biochim. Biophys. Acta 2014, 1843, 2685–2697. [Google Scholar] [CrossRef] [PubMed]

| Strain | Relevant Genotype | Requirements |
|---|---|---|
| HHO4 | Huade2::kanMX/HuADE2 | none |
| HHO12 | Huade2::loxP/HuADE2 | none |
| HHO7 | Huade2::kanMX/Huade2::hph | adenine |
| HHO20/HHO21 | Huade2::loxP/Huade2::loxP | adenine |
| HHO2 | Huhis3::kanMX/HuHIS3 | none |
| HHO17 | Huhis3::loxP/HuHIS3 | none |
| HHO14 | Huhis3::kanMX/Huhis3::hph | histidine |
| HHO31/HHO32 | Huhis3::loxP/Huhis3::loxP | histidine |
| HHO25 | Huleu2::hph/HuLEU2 | none |
| HHO37 | Huleu2::loxP/HuLEU2 | none |
| HHO40 | Huleu2::loxP/Huleu2::hph | leucine |
| HHO44 | Huleu2::loxP/Huleu2::loxP | leucine |
| HHO6 | Huura3::hph/HuURA3 | none |
| HHO19 | Huura3::loxP/HuURA3 | none |
| HHO29 | Huura3::loxP/Huura3::hph | uridine 1 |
| HHO33/HHO35 | Huura3::loxP/Huura3::loxP | uridine 1 |
| Strain | Procedure 1 | Plasmid 2 | Selection | Transformants/µg 3 |
|---|---|---|---|---|
| HHO1 | EP | pJJH3181 | hygromycin | 5.0 × 105 |
| HHO1 | EP | pJJH3182 | hygromycin | 2.4 × 105 |
| HHO1 | EP | pJJH3200 | hygromycin | 5.0 × 105 |
| HHO1 | FM | pJJH3200 | hygromycin | 4.0 × 105 |
| HHO21 | FM | pJJH3228 | SC w/o adenine | 1.3 × 105 |
| HHO31 | EP | pJJH3253 | SC w/o histidine | 0.2 × 105 |
| HHO31 | FM | pJJH3253 | SC w/o histidine | 0.5 × 105 |
| HHO40 | FM | pJJH3252 | SC w/o leucine | 1.8 × 105 |
| HHO35 | FM | pJJH3259 | SC w/o uracil | 6.0 × 105 |
Disclaimer/Publisher’s Note: The statements, opinions and data contained in all publications are solely those of the individual author(s) and contributor(s) and not of MDPI and/or the editor(s). MDPI and/or the editor(s) disclaim responsibility for any injury to people or property resulting from any ideas, methods, instructions or products referred to in the content. |
© 2023 by the authors. Licensee MDPI, Basel, Switzerland. This article is an open access article distributed under the terms and conditions of the Creative Commons Attribution (CC BY) license (https://creativecommons.org/licenses/by/4.0/).
Share and Cite
Heinisch, J.J.; Murra, A.; Jürgens, K.; Schmitz, H.-P. A Versatile Toolset for Genetic Manipulation of the Wine Yeast Hanseniaspora uvarum. Int. J. Mol. Sci. 2023, 24, 1859. https://doi.org/10.3390/ijms24031859
Heinisch JJ, Murra A, Jürgens K, Schmitz H-P. A Versatile Toolset for Genetic Manipulation of the Wine Yeast Hanseniaspora uvarum. International Journal of Molecular Sciences. 2023; 24(3):1859. https://doi.org/10.3390/ijms24031859
Chicago/Turabian StyleHeinisch, Jürgen J., Andrea Murra, Kai Jürgens, and Hans-Peter Schmitz. 2023. "A Versatile Toolset for Genetic Manipulation of the Wine Yeast Hanseniaspora uvarum" International Journal of Molecular Sciences 24, no. 3: 1859. https://doi.org/10.3390/ijms24031859
APA StyleHeinisch, J. J., Murra, A., Jürgens, K., & Schmitz, H.-P. (2023). A Versatile Toolset for Genetic Manipulation of the Wine Yeast Hanseniaspora uvarum. International Journal of Molecular Sciences, 24(3), 1859. https://doi.org/10.3390/ijms24031859

